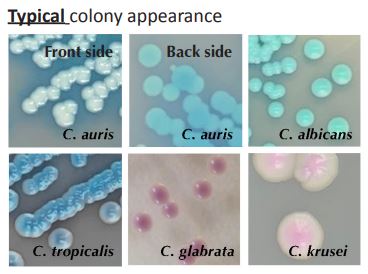

@LIFEworld @LIFEworld |
|
NEWSLETTER - November 2024
Welcome to the new LIFE Worldwide quarterly newsletter. We aim to bring you the latest developments in the world of Medical Mycology, including breaking news, diagnostic innovations and literature reviews.
|
|
Global health roundup - Histoplasmosis in Brasil
|
|
A new study into the treatment of histoplasmosis with various formulations of Amphotericin B (AmB) in Brazil. Conducted from January 2014 to December 2019 across seven Brazilian tertiary medical centres, including 215 patients, 87% of whom had HIV. D-AmB was the predominant formulation given but was linked to higher mortality and adverse events. L-AmB, though less frequently used, showed better outcomes and fewer adverse events.
The study suggests the need for further research on the effectiveness of L-AmB to improve treatment outcomes for histoplasmosis in Brazil, and across the world. This project emphasises the importance of making L-AmB more available in the public health system for treating severe histoplasmosis. It also highlights the critical need for better treatment options and availability of L-AmB to reduce mortality and adverse events in histoplasmosis patients, particularly those with HIV. Read more here.
|
| Latest news |
|
AZOLE-RESISTANT ASPERGILLUS FUMIGATUS FOUND ON HOSPITAL EQUIPMENT
A paper from Ghazanfari et al,shows an alarming occurrence of azole-resistant A.fumigatus within hospital equipment. Across Iran, 23 teaching hospitals participated in the
study and samples were collected from the surface of medical equipment and appliances (such as computers, ventilators, anaesthesia machines, and pacemakers) in different wards (including ICU, neonatal ICU (NICU),operating room, general, and oncology wards). MORE INVASIVE FUNGAL INFECTIONS IN ANCA-ASSOCIATED VASCULITIS
A new case-based review published in Clinical Rheumatology highlights the precarious situation faced by patients with anti-neutrophil cytoplasmic antibody (ANCA)-associated vasculitis (AAV) when complicated by invasive fungal infections (IFIs). The review, authored by Dr. Sahana Baliga and colleagues from the PD Hinduja National Hospital and Medical Research Centre, underscores the high mortality and diagnostic difficulties associated with these concurrent conditions.
Diagnostic tip - New Candida Auris diagnostic tool
There is a new diagnostic tool available to help identify Candida strains. CHROMagar™ CandidaPlus is a chromogenic culture medium to detect, differentiate and quantify and Candida species including C. auris. The test can be performed with swabs from skin, throat, ears and vaginal specimens, as well as sputum, urine and stools samples, in parallel to cultures on Sabouraud agar, to aid in the Candidiasis diagnosis. Results can be interpreted after 24-48h of aerobic incubation at 30-37°C.
Have a look at our free, online diagnostic learning platform: www.microfungi.net
Fig. 1 - diagnostic images from CHROMagar™ CandidaPlus test.
|
|
Review - Antifungal susceptibility testing
With increasing antifungal resistance, comes the need for antifungal susceptibility testing (AFST). To address the general lack of AFST in resource-constrained settings, a recent review of the methods for AFST (broth microdilution, disc diffusion, gradient diffusion strips, and agar-based screening) proposed seven steps for implemention in resource-constrained settings. These steps are securing local or other funding, providing laboratory and clinical training, establishing clear protocols, ensuring access to media and reagents, acquiring quality control strains, and participating in external quality assurance programs. Political commitment and international collaborations will be essential for enabling AFST service delivery in every teaching hospital.
Coming up
International Congress on Infectious Diseases. Cape Town, South Africa, 3-6 Dec 2024.
|
| www.fungaleducation.org |